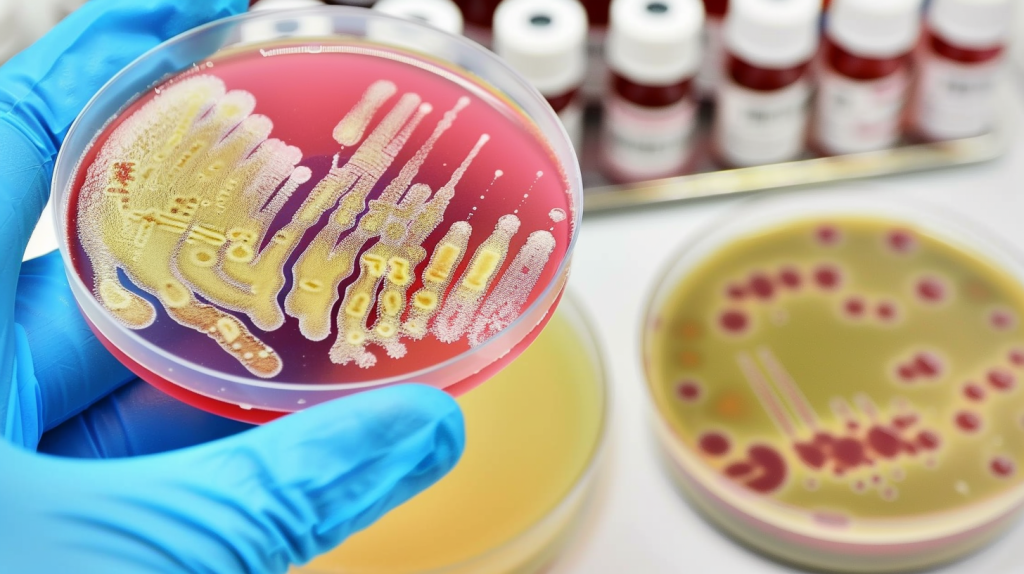

Сепсис это серйозний і дуже небезпечний стан, який виникає тоді, коли організм надто сильно реагує на інфекцію. Спочатку інфекція може здаватися звичайною, наприклад, ангіною або запаленням легенів. Однак з часом реакція тіла стає надмірною. У результаті імунна система починає шкодити власним органам. Саме тому сепсис це не просто ускладнення, а загроза для життя. Тому важливо знати основні симптоми та діяти швидко.
Що означає сепсис это простими словами
Сепсис это стан, при якому інфекція поширюється по всьому організму через кров. Проте справа не лише в мікробах. Насамперед небезпеку створює сильна запальна реакція. Організм намагається боротися з бактеріями або вірусами, але водночас ушкоджує власні тканини. У результаті можуть страждати серце, легені, нирки та мозок. Саме тому лікарі вважають, що сепсис це критичний стан, який потребує термінової допомоги.
Чому виникає сепсис это небезпечний процес
Сепсис это наслідок інфекції, яка не була вчасно зупинена. Наприклад, він може початися через пневмонію, інфекцію сечових шляхів або зараження рани. Крім того, ризик зростає після операцій. Особливо небезпечно, якщо людина має слабкий імунітет. Таким чином, сепсис це не окрема хвороба, а реакція на іншу проблему. І саме тому важливо лікувати будь-яку інфекцію вчасно.
Основні симптоми сепсис это сигнал небезпеки

Сепсис этоо стан, який має чіткі ознаки. По-перше, піднімається температура або навпаки вона падає дуже низько. По-друге, з’являється сильна слабкість. Крім того, серце починає битися швидше. Людина може відчувати задишку. Іноді шкіра стає блідою або синюватою. Також можливі сплутаність свідомості та різке зниження тиску. Отже, якщо ви помітили кілька таких симптомів одночасно, потрібно негайно звернутися до лікаря.
Стадії сепсис этоо розвиток у часі
Сепсис этоо процес, який може розвиватися поступово або дуже швидко. Спочатку з’являється системна запальна реакція. Далі, якщо лікування відсутнє, настає важкий сепсис. У цей момент органи вже працюють гірше. А згодом може виникнути септичний шок. Тоді тиск падає настільки сильно, що кров не може нормально живити органи. Саме тому лікарі завжди підкреслюють: чим раніше почати лікування, тим більше шансів на одужання.
Як лікарі визначають сепсис этоо діагностика
Сепсис этоо стан, який лікарі діагностують за кількома критеріями. Спочатку вони оцінюють симптоми. Далі беруть аналіз крові. Крім того, перевіряють рівень кисню та тиску. Часто роблять рентген або ультразвук, щоб знайти джерело інфекції. Таким чином, діагностика включає одразу кілька кроків. І хоча аналізи займають час, лікування зазвичай починають одразу.
Лікування сепсис этоо невідкладна допомога
Сепсис этоо стан, який лікують у лікарні. Перш за все лікарі вводять антибіотики. Також пацієнту дають рідину через крапельницю. Крім того, за потреби підключають кисень або апарат штучної вентиляції легень. Іноді лікарям доводиться проводити операцію, щоб видалити джерело інфекції. Отже, лікування залежить від причини та стану людини. Проте головне правило одне — діяти швидко.
Чому сепсис этоо особливо небезпечно для дітей і літніх
Сепсис этоо стан, який найчастіше ускладнює життя дітям та людям похилого віку. У дітей імунна система ще не повністю сформована. А в літніх людей вона вже ослаблена. Тому інфекція може поширитися швидше. Крім того, симптоми можуть бути не такими очевидними. Саме тому батьки та родичі повинні бути уважними до будь-яких змін у самопочутті.
Як запобігти сепсис это профілактика
Сепсис этоо небезпечний стан, але його можна попередити. По-перше, потрібно вчасно лікувати інфекції. По-друге, важливо мити руки та дотримуватися гігієни. Крім того, вакцинація допомагає знизити ризик деяких інфекцій. Також важливо правильно обробляти рани. Якщо з’являється почервоніння або біль, потрібно звернутися до лікаря. Таким чином, профілактика починається з простих дій.
Ускладнення сепсис этоо довгострокові наслідки
Сепсис этоо стан, який може залишити наслідки навіть після одужання. Деякі люди відчувають слабкість протягом місяців. Крім того, можуть виникати проблеми з пам’яттю. Іноді страждають нирки або серце. Саме тому реабілітація дуже важлива. Поступово організм відновлюється, але для цього потрібен час.
Чому важливо говорити про сепсис этоо інформація рятує життя
Сепсис это проблема, про яку знають не всі. Однак знання допомагає вчасно розпізнати небезпеку. Якщо людина розуміє симптоми, вона швидше звертається до лікаря. А отже, шанси на виживання зростають. Саме тому лікарі та медіа все частіше розповідають про цей стан. Інформація справді може врятувати життя.
Висновок про сепсис это серйозний виклик
Сепсис это надзвичайно небезпечний стан, який виникає через сильну реакцію організму на інфекцію. Проте, якщо діяти швидко, його можна подолати. Тому важливо знати симптоми, причини та методи лікування. Крім того, профілактика відіграє ключову роль. Бережіть своє здоров’я та не ігноруйте тривожні сигнали.
Читати далі: Що таке консенсус – простими словами про досягнення згоди
Часті запитання про сепсис это поширені запитання
Ні, сепсис це не заразна хвороба. Проте інфекція, яка його викликала, може передаватися.
Ні, сепсис це не завжди смертельно. Однак без лікування ризик дуже високий.
Часто люди так говорять, проте сепсис це ширше поняття. Він включає сильну реакцію організму на інфекцію.
Сепсис это можна лікувати вдома?Ні, сепсис це стан, який потребує госпіталізації та постійного контролю лікарів.
Так, сепсис це може розвинутися навіть після звичайної інфекції, якщо її не лікувати або якщо імунітет ослаблений.
